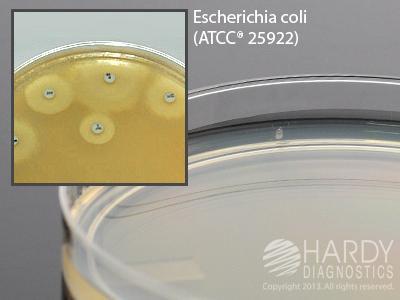

Mueller Hinton Agar 15x100mm Plate , Pack Of 10
$ 20.20
|
|
Details:
Mueller Hinton Agar^ For disk susceptibility testing, 28ml fill, 15x100mm plate, order by the package of 10, This is the smaller Mueller Hinton plate that will hold up to five antimicrobial disks. Polystyrene Petri plates feature raised rings for stacking ability and prevents sliding.
Additional Information
| SKU | 23436233 |
|---|---|
| UOM | Pack of 10 |
| UNSPSC | 41106200 |
| Manufacturer Part Number | G45 |
| Product Dimensions | 4X4X8 Inches |
| Product Weight | 1 |
